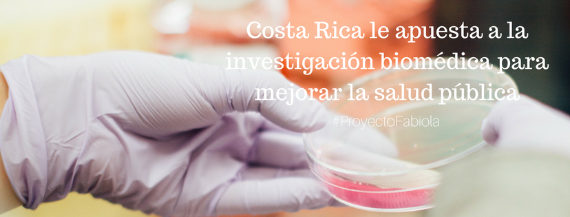

Después de cuatro meses de mucho esfuerzo, llegó la hora de premiar el mejor trabajo periodístico producido en la #Clase3 de Punto y Aparte.
El jurado encargado de esta difícil tarea será:
Kattia Bermudez: Es una periodista muy respetada que ha hecho carrera tanto en medios de comunicación como dentro de las aulas universitarias. Actualmente trabaja en La Nación y en la UCR. En 1999, Kattia recibió el Premio Nacional de Periodismo Jorge Vargas Gené a la cobertura especializada en temas económicos.
Juan Pablo Carranza: Es un periodista con 15 años de experiencia en digital. Laboró como reportero y editor en los diarios Al Día y La Nación, además de desarrollar las áreas de video online, producción web y redes sociales. Hoy se dedica al marketing digital, área en la que ha dirigido estrategias para canales sociales de marcas como Oreo, el TEC, Movistar y Coca-Cola a nivel regional.
Hässel Fallas: Destaca, entre muchas otras cosas, por su capacidad para dirigir y ejecutar proyectos de investigación periodística por medio del análisis de bases de datos. Actualmente es la Editora Unidad de Inteligencia de Datos e investigación.
Estos son los trabajos que evaluarán:
Fabiola Madrigal Cubillo
Costa Rica le apuesta a la investigación biomédica para mejorar la salud pública.
Manuel Mojica RojasPendiente su publicación
José Pablo Román BarzunaCosta Rica: tierra fértil para esclavos
Loly Abarca FurnissEstudiar en la cárcel: una oportunidad para salir adelante
Nathalia Villabobos RamírezTurismo en el Golfo Dulce: entre la conservación y el desarrollo
Valeria Navas CastilloCultivo de piña quiebra los escudos contra cambio climático
Ayleth Álvarez LedezmaSólo 4 de cada 100 transexuales logran ganar secundaria
Armando Quesada WebbLa Agricultura: un oficio sin herederos
Ericka Arroyo MasísPublicación Pendiente